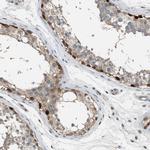
Torc1 Antibody in Immunohistochemistry (Paraffin) (IHC (P))

Search
Invitrogen
Torc1 Polyclonal Antibody
{{$productOrderCtrl.translations['antibody.pdp.commerceCard.promotion.promotions']}}
{{$productOrderCtrl.translations['antibody.pdp.commerceCard.promotion.viewpromo']}}
{{$productOrderCtrl.translations['antibody.pdp.commerceCard.promotion.promocode']}}: {{promo.promoCode}} {{promo.promoTitle}} {{promo.promoDescription}}. {{$productOrderCtrl.translations['antibody.pdp.commerceCard.promotion.learnmore']}}
产品信息
PA5-82786
种属反应
已发表种属
宿主/亚型
分类
类型
抗原
偶联物
形式
浓度
规格
纯化类型
保存液
内含物
保存条件
运输条件
RRID
产品详细信息
Immunogen sequence: SPPADTSWRR TNSDSALHQS TMTPTQPESF SSGSQDVHQK RVLLLTVPGM EETTSEADKN LSKQAWDTKK TGSRPKSCEV
Highest antigen sequence indentity to the following orthologs: Mouse - 84%, Rat - 86%.
靶标信息
Transcriptional coactivator for CREB1 which activates transcription through both consensus and variant cAMP response element (CRE) sites. Acts as a coactivator, in the SIK/TORC signaling pathway, being active when dephosphorylated and acts independently of CREB1 'Ser-133' phosphorylation. Enhances the interaction of CREB1 with TAF4. Regulates the expression of specific CREB-activated genes such as the steroidogenic gene, StAR. Potent coactivator of PGC1alpha and inducer of mitochondrial biogenesis in muscle cells. In the hippocampus, involved in late-phase long-term potentiation (L-LTP) maintenance at the Schaffer collateral-CA1 synapses. May be required for dendritic growth of developing cortical neurons. In concert with SIK1, regulates the light-induced entrainment of the circadian clock. In response to light stimulus, coactivates the CREB-mediated transcription of PER1 which plays an important role in the photic entrainment of the circadian clock. [UniProt]
仅用于科研。不用于诊断过程。未经明确授权不得转售。
生物信息学
蛋白别名: CREB-regulated transcription coactivator 1; crtc1; FLJ14027; Mastermind-like protein 2; MECT 1; mucoepidermoid carcinoma translocated 1; Mucoepidermoid carcinoma translocated protein 1; Mucoepidermoid carcinoma translocated protein 1 homolog; TORC-1; transcriptional co-activator; transducer of CREB protein 1; transducer of regulated cAMP response element-binding protein (CREB) 1; Transducer of regulated cAMP response element-binding protein 1; unnamed protein product
基因别名: AI413414; CRTC1; KIAA0616; Mam-2; MAML2; MECT1; mKIAA0616; R74955; TORC-1; TORC1; WAMTP1
UniProt ID: (Human) Q6UUV9, (Rat) Q157S1, (Mouse) Q68ED7
Entrez Gene ID: (Human) 23373, (Rat) 684527, (Mouse) 382056